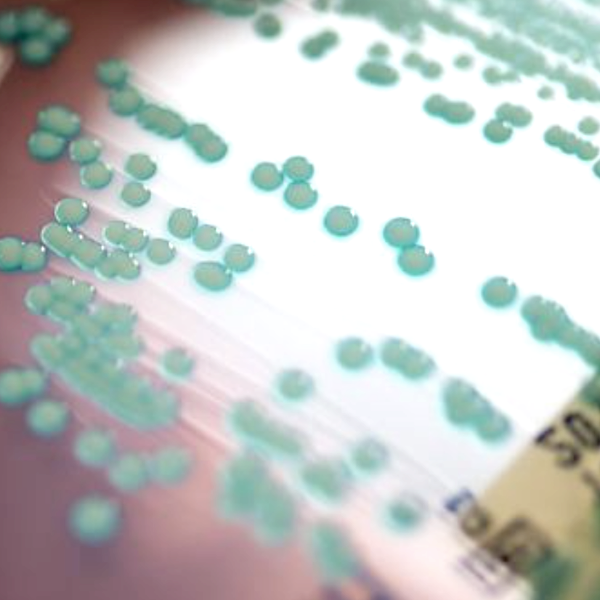

Поиск
Полезное

06.11.2025

31.05.2025
Подписка
Места

26.01.2025

16.04.2023

16.04.2023

16.04.2023

.png)





